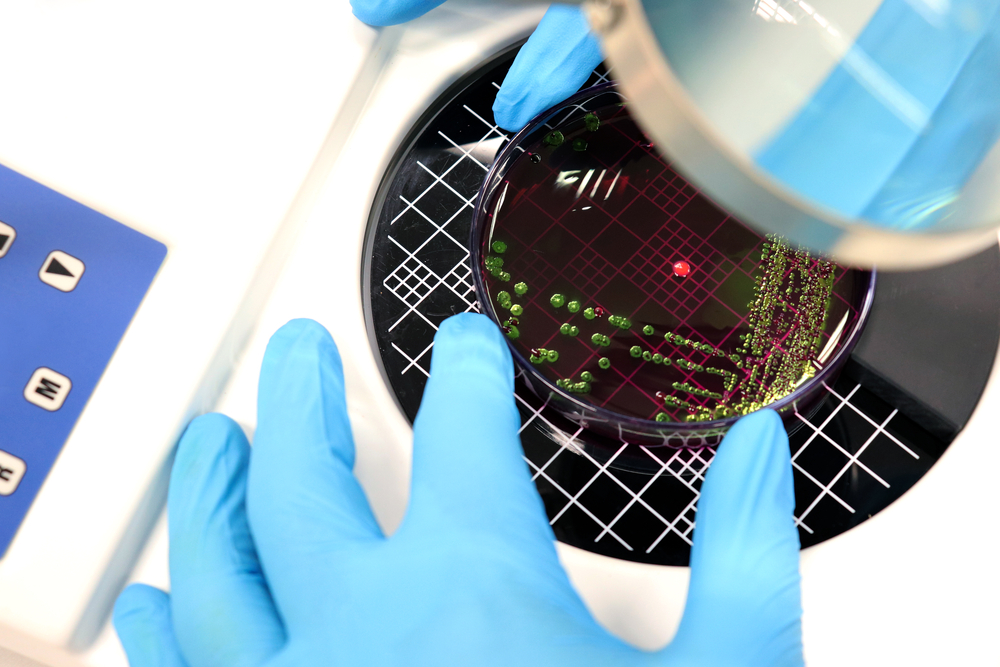

Classical methodologies and current limitations
Switching from a liquid medium to sold agar plates in the early 1800s was a significant change for microbiology sciences. Operational standardisation of plate counting evolved at such a rapid pace that it quickly became the default quality control (QC) method, allowing for better bacterial isolation and quantification, and significantly decreasing contamination rates in bacterial purification processes.
Colony-forming units (CFU) counting constitutes a simple method widely found in current standards, which explains why it remains the current practice in Live Biotherapeutic Product (LBP) quality control protocols throughout the production and scaling processes worldwide – despite it first being introduced over 200 years ago.
However, despite its multiple benefits, CFU-counting methodologies have inherent constraints (time and strain-wise) that have become particularly obvious with the rise of modern microbiome products such as ‘Next Generation Probiotics’ (NGP).
Some of the limitations of CFU-based enumeration include:
- Slow iteration: days-long incubation delays decisions during process development and troubleshooting.
- Undercounting or biased readings: some bacteria can enter a dormant but metabolically active state that will not form colonies in that specific culturing condition but might reactivate at a later stage. This state is known as ‘viable but not culturable’ (VBNC). As these bacteria do not properly form CFU, they can get lost throughout the isolation process, leading to falsely ignoring their presence in the original mix.
- Not fit-for-purpose for ‘next-generation’ strains: strict anaerobes and novel gut commensals can be difficult to culture consistently; in this context CFU counting becomes unsuitable as the sole enumeration method.
Many NGP candidates are based on strict anaerobe strains, with demanding growth requirements; industrial production steps (concentration, freezing, drying, storage) can push cells into VBNC states. When strains are difficult to culture, and timelines are tight, the time needed to cultivate a colony can easily become a bottleneck.
At Biose Industrie, we understand this challenge, and as a CDMO specialising in both LBP and NGP development, we are deeply committed to bringing pharmaceutical-grade manufacturing discipline to difficult-to-culture organisms and complex production workflows, all the while staying abreast with the state-of-the-art technology.
Modern microbial characterisation: AFU technology
While CFU-counting is the gold standard in microbial-based therapeutics regulatory standards, it is not the only available technique for bacterial characterisation. In the 1990s, flow cytometry (FCM)-based bacterial analysis arose as a faster alternative to CFU-counting, which bloomed in the 2000s with the development of different dyes used to discriminate between live and dead bacteria.
FCM bacterial characterisation has arisen as a robust alternative to overcome most of the limitations faced by CFU-counting for NGPs, especially since its international recognition in the regulatory landscape by ISO 19344 IDF 232 for the quantification of active and/or total bacteria in probiotic products.
According to this regulation, cells are primarily stained with fluorescent dyes that allow for live/dead state discrimination, after which they are analysed in a one-by-one manner as they pass through a laser. Further processes of fluorescent-based separation split active/intact cells from damaged/non-active cells. As the main goal is the identification and quantification of live cells, these are often referred to as Active Fluorescent Units (AFU).
Biose’s approach to become the reference in NGP manufacturing
After more than 9 years as a leading CDMO for microbiome therapeutics, we aim to offer each market segment what it requires:
- For LBPs (drug/medicinal products with microorganisms as active ingredients), bacterial specificity and quantity are critical points. Overestimation of the bacterial concentration or potential uncertainty about the mix composition becomes a drug potency issue, alongside a potential safety issue. That is why, following international regulation (FDA guidance), manufacturing is tightly controlled using CFU-based techniques. The FDA, however, does propose implementing alternative methods (see USP 1223).
- For NGPs (dietary/food supplements with microorganisms as active ingredients), the product is expected to be dominated by the intended microorganism(s), which is why ISO methodology can be acceptable as long as the QC systems effectively control for the expected purity and the method is adequately validated.
How we include AFU in our processes
AFU fits naturally across three manufacturing phases:
- Upstream growth & scale-up: providing rapid confirmation that concentration and population “fitness” are on track to continue with the seed train process.
- Downstream recovery & concentration: bacterial collection and concentration are known to severely affect bacterial viability and integrity. Applying AFU-based enumeration between the independent steps is paramount when identifying potential bottlenecks in optimisation processes, improving overall bacterial recovery rates.
- Formulation & finishing: using AFU enumeration to track how the active fraction survives the drying stage and evolves during storage allows for the improvement of shelf-life and process robustness.
Operationally, the goal is efficiency with confidence. Clients can request AFU tracking between steps to confirm targets and verify final batch quality, but they can also ask for AFU application to multiple small samples to confirm a given batch is truly consistent.
At Biose, we have a strong commitment to providing the best quality standards while making use of the most innovative technology. This is why we have incorporated AFU bacterial characterisation for several strains among our services to ensure our clients have more accurate and faster feedback times, smaller sampling burdens, and an instantaneous with higher accuracy in-process control. We are now leveraging our deep expertise in microbiome products to optimise the QC processes of NGP production and scaling, so our clients can continue to innovate in the field, knowing their products are compliant with the latest regulatory requirements.